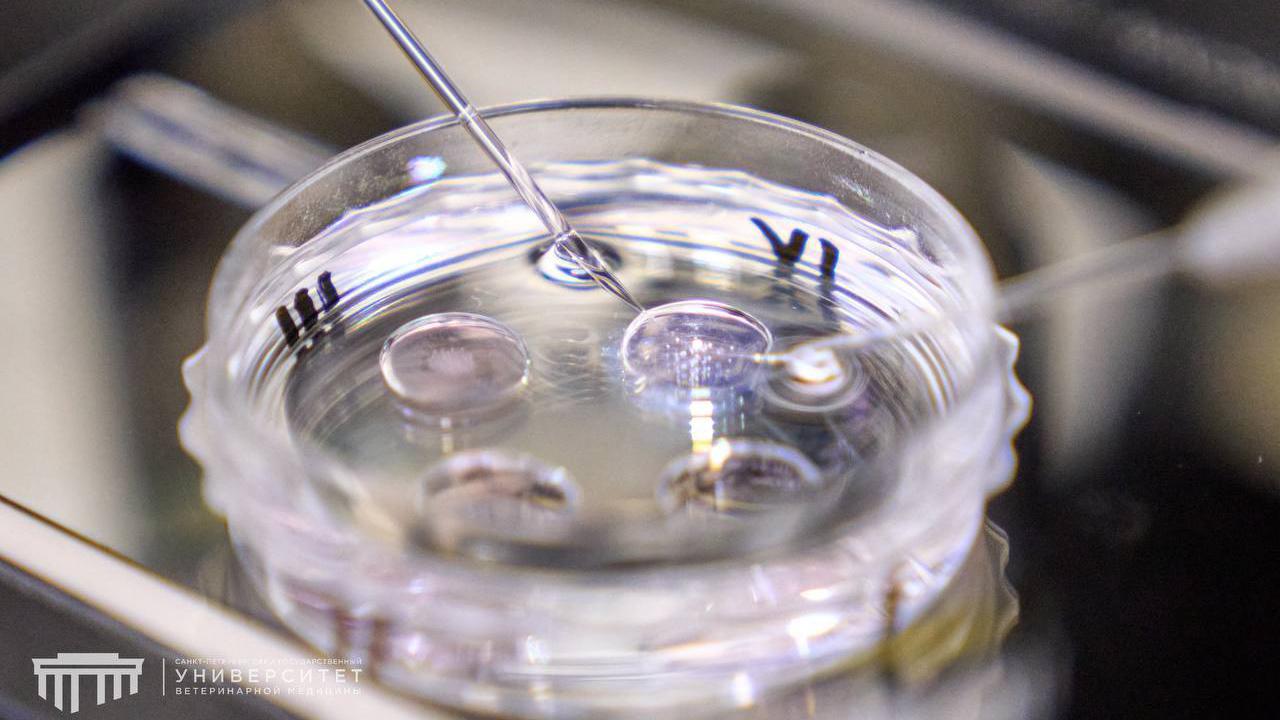
#

Петербургские учёные представили телёнка «из пробирки»

Учёные Санкт-Петербургского государственного университета ветеринарной медицины (СПбГУВМ) совместно с племенным заводом «Бугры» представили искусственно выращенного телёнка. Он был получен в лаборатории университета методом экстракорпорального оплодотворения (IVP). Телёнок обладает высокими генетическими показателями.
Отец новорождённого — геномно-оценённый бык голштинской породы «Баркип» из США, обладающий одним из лучших показателей племенной ценности в мире (TPI 3490). Мать телёнка — высокопродуктивная корова из Ленинградской области с рекордным удоем свыше 14 тонн молока за 305 дней лактации.
Технология IVP включает несколько этапов: получение и дозревание ооцитов, оплодотворение, культивирование эмбрионов на протяжении 6–7 суток, криоконсервация, подсадка эмбрионов корове-реципиенту и рождение телёнка через 278 дней. Этот метод позволяет ускорить селекцию до 40 %.
Ректор университета Кирилл Племяшов выразил гордость за работу команды:
— Когда ты держишь в руках результат многолетней работы — пусть даже он весит всего несколько десятков килограммов и стоит на четырёх ногах — это особенное чувство, — отметил он.
Ранее 78.ru сообщал, что Петербург направит 3 миллиона рублей на поддержку исследований в сфере сельского хозяйства.